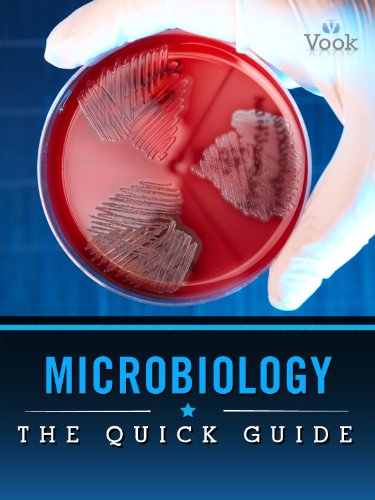

Microbiology: The Quick Guide
Product ID: B0052PQ480
Condition: USED (All books in used condition)
No Stock / Cannot Import
Product Description
Condition - Very Good
The item shows wear from consistent use but remains in good condition. It may arrive with damaged packaging or be repackaged.
Microbiology: The Quick Guide
This digital compendium highlights all of the key components of the study from classification to disease and technology. Engaging and succinct text gets you quickly to the heart of each entry.
You’ll gain valuable insight into:
- Organisms
- Phases of Growth
- Photosynthesis
- Mutations
- Viruses
- Old and New Classification
- Pathogens
...and more.
Technical Specifications
Country
USA
Author
Vook
Binding
Kindle Edition
EISBN
9781614301851
Format
Kindle eBook
Label
Vook
Manufacturer
Vook
NumberOfPages
34
PublicationDate
2011-05-25
Publisher
Vook
ReleaseDate
2011-05-25
Studio
Vook





